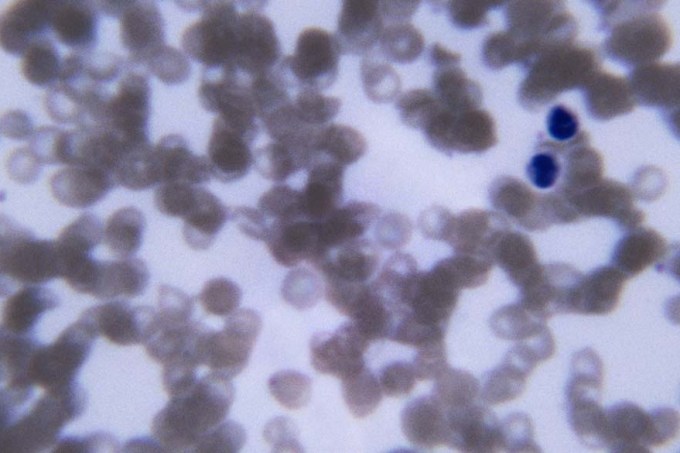

A liberação da técnica inovadora para edição genética CRISPR-Cas9 no Reino Unido e Estados Unidos está voltando os olhos do mundo para uma grave condição que afeta a rotina dos pacientes por causar dores intensas e que pode levar à morte: a doença falciforme. Causada por mutações que alteram o formato das hemácias, que adquirem o formato de foice (daí o nome), a doença impacta também na expectativa de vida das pessoas. Esse foi o achado de um novo estudo, obtido com exclusividade por VEJA, que mostrou que ela é responsável por reduzir a sobrevida em 37 anos em comparação à população geral no Brasil.
O estudo, publicado na revista científica Blood Advances, editada pela Sociedade Americana de Hematologia, teve como base dados de certidões de óbitos do período de 2015 a 2019, quando foram registradas 6.553.132 mortes, das quais 3.320 foram de pacientes com a condição. Com esse recorte, foi constatado que a idade mediana ao morrer era de 69 anos na população geral e caía para 32 anos entre as pessoas com doença falciforme.
“A redução de 37 anos de expectativa de vida desses pacientes é um misto tanto de complicações agudas e crônicas que eles têm ao longo da vida e também a dificuldade do tratamento adequado dessas complicações no SUS (Sistema Único de Saúde)”, diz Ana Cristina Silva Pinto, médica da Fundação Hemocentro de Ribeirão Preto (SP) e uma das autoras do estudo.
Entre os problemas para o tratamento apontados por Ana Cristina, que também é professora da Universidade de São Paulo (USP), estão: falta de leitos de Unidade de Terapia (UTI) e para hospitalização, dificuldade de acesso a unidades de emergência bem equipadas e a equipes com conhecimento sobre doença falciforme.
Ainda de acordo com a pesquisa, o risco de morte na faixa etária de 1 a 9 anos foi 32 vezes maior do que nas crianças que não vivem com a doença. Na população de 10 a 39 anos, o risco foi 13 vezes maior.
Continua após a publicidade
“É importante que os gestores saibam que os pacientes enfrentam ao longo da sua vida com a linha de cuidado com a doença. Alguns pacientes estão em centros de referência, mas não conseguem comunicação com a rede básica de saúde, que é mais perto da casa dele e onde vai ser atendido em uma urgência, porque precisa viajar horas para um centro de referência”, explica.
População preta e parda
Também chamada de anemia falciforme, a doença afeta mais pessoas pretas e pardas. Essa também é a população que mais registrou óbitos, de acordo com o estudo, contabilizando 78,6% dos desfechos fatais, dos quais 52,2% foram em mulheres. As principais causas de morte foram septicemia, mais conhecida como infecção generalizada, e insuficiência respiratória.
Em outubro, o Ministério da Saúde apresentou, pela primeira vez, uma panorama sobre a doença. São estimados 60 mil a 100 mil casos no país e foi estabelecido que a notificação agora é compulsória.
Segundo Ana Cristina, a medida é fundamental para dar suporte adequado aos pacientes. “Hoje, temos uma variação de casos muito grande e precisamos de números fidedignos para direcionar as políticas públicas.”
Continua após a publicidade
Doença falciforme
Detectada pelo teste do pezinho, teve incidência no Brasil de um caso a cada 2,5 mil nascidos vivos entre 2014 e 2020. A mortalidade por doença falciforme foi de 0,22 a cada 100 mil habitantes, especialmente na população de 20 a 29 anos.
Também chamada de anemia falciforme, ela se caracteriza por uma mutação no gene que produz a hemoglobina, resultando em glóbulos vermelhos do sangue (hemácias) em formato de foice ou meia lua, quando deveriam ser redondos. Pessoas com esse quadro podem ter anemia, crises de dor, má circulação e complicações renais.
O tratamento atualmente consiste em transfusões de sangue, medicamentos e, tendo um doador compatível, transplante de medula. A nova aposta é o uso da terapia de edição do DNA CRISPR-Cas9, laureada com o Nobel de Química em 2020. Recém-aprovada no Reino Unido e nos Estados Unidos, ela custa cerca de 2 milhões de dólares por paciente.